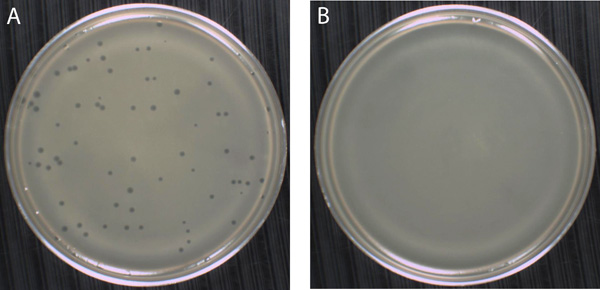

Principe Essai De Plaque

Le module de compressibilité et.
Principe essai de plaque. Une moyenne des 3 déformations mesurées à chaque impact sous la plaque de 30 cm de diamètre permet de calculer instantanément le module de déformation dynamique evd. On peut prendre un camion une grue ou un bulldozer comme contrepoids. L essai s applique aux plates formes d ouvrages de terrassement et d assainissement.
Cet essai peut être réalisé sur le sol un remblai une sous fondation ou une fondation. Ces valeurs s affichent directement à l écran du boîtier électronique à chaque essai. La réalisation de cet essai en faisant référence aux normes tout en ne respectant pas strictement les distances entre la surface d appui du massif et la plaque peut être acceptée dans les conditions suivantes pour les mesures à réaliser en cas de doute de contentieux ou relevant.
La résistance 120 ohms est petite et laisse passer beaucoup de courant c est pourquoi la led est très lumineuse. Le module ev2 en mpa et l indice cbr en peuvent ensuite être calculés. La plaque installée au sol à l aide d un dispositif hydraulique actionné par l opérateur haxea est soumise à 3 chocs.
Le principe de cet essai consiste à charger une plaque et d enregistrer le tassement de la plaque pendant le chargement. La plaque est un plateau de charge circulaire normé mis en charge et déchargé à plusieurs reprises par un dispositif de pression sur le substrat à une certaine pression et à un certain. Plus la résistance est forte moins elle.
La plaque dynamique légère est un essai de portance dynamique par masse tombante. Cette technique repose sur des bandes adhésives noires réfléchissantes en forme de chiffre. Les essais à la plaque sont principalement d application dans la construction routière où il convient de contrôler les caractéristiques élastiques de la route posée.
Objectif principe bonnes pratiques l objectif de l essai à la plaque est de mesurer la portance d une plateforme. Les chiffres autocollants. L essai à la dynaplaque est réalisé en faisant chuter une masse sur un ressort amortisseur lui même placé sur une plaque rigide d un diamètre de 600 mm.